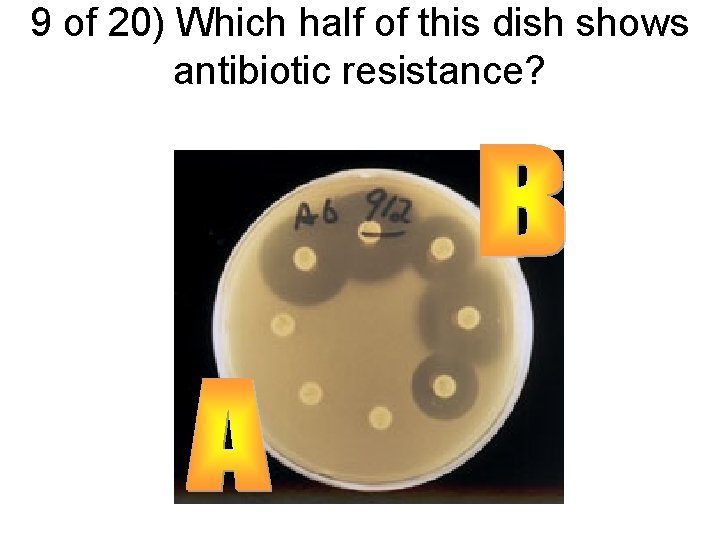
9 of 20) Which half of this dish shows antibiotic resistance?
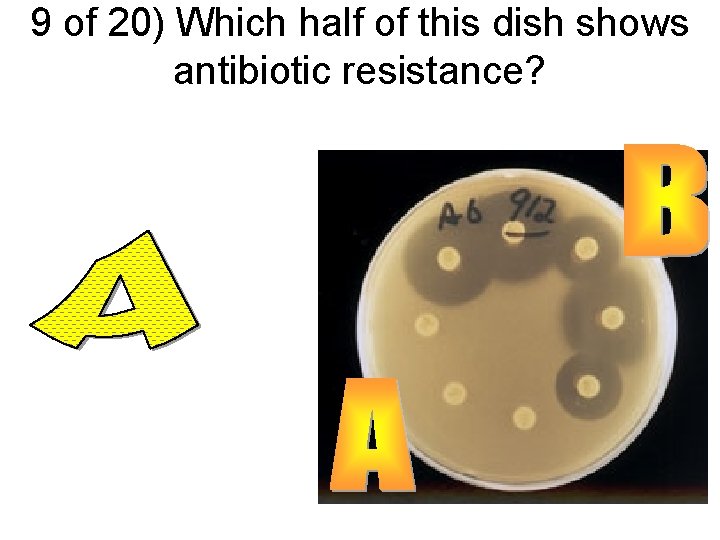
9 of 20) Which half of this dish shows antibiotic resistance?

Evolution Challenge After each question write your answer

- Slides: 42
Evolution Challenge • After each question, write your answer on your paper. You will be given about 30 seconds per questions. We will correct all questions at the end. The group with the most correct answers will win a bonus extra credit point.
1 of 20) Name the famous theory developed by Charles Darwin.
2 of 20) What are advantageous traits called?
3 of 20) What are the differences between these cows called?
4 of 20) Which mechanism of evolution happens as a result of natural disasters and not natural selection?
5 of 20) Which fossil(s) is/are younger than fossil B?
6 of 20) These 2 plants are found on opposite ends of the world yet they share many physical traits. What do they share in common?
7 of 20) What is the problem with ligers produced from the male lion and female tiger?
8 of 20) Which type of isolation is shown in this picture?
9 of 20) Which half of this dish shows antibiotic resistance?
10 of 20) What is the process called when many species evolve from 1 original ancestral species?
11 of 20) Four part question: During the Great Bean Hunt… a. Which prey was best adapted? b. Which prey was least adapted? c. Which predator was best adapted? d. Which predator was least adapted?
12 of 20) Which isolation prevents groups of organisms from reproducing due to different seasons?
13 of 20) What are gaseous clouds that stars form from called?
14 of 20) C 12 and C 14 are both carbon because they each have 6 protons. Three part question: a) How many neutrons does C 12 contains? b) How may neutrons does C 14 have? c) C 12 and C 14 are examples of what kind of atom?
15 of 20) Place the astronomical objects in order of smallest to largest. a. Satellite b. Galaxy c. Star d. Planet e. Universe f. Solar system
16 of 20) Which isolation prevents groups of organisms from reproducing due to different mating rituals?
17 of 20) Name 3 (of the 4) gases that Miller and Urey added to their gas chamber to simulate the early atmosphere of Earth.
18 of 20) Name the two types of extinctions.
19 of 20) Two part question: a) Which body parts have lost most or all of their functions? b) Which body parts are similar in structure but differ in function?
20 of 20) Grab-Bag: Which model car has been sold the most throughout history? Toyota Corolla Chevrolet Corvette Volkswagen Beetle Ford Model T BMW 3 series
Exchange your answers!
1 of 20) Name the famous theory developed by Charles Darwin.
2 of 20) What are advantageous traits called?
3 of 20) What are the differences between these cows called?
4 of 20) Which mechanism of evolution happens as a result of natural disasters and not natural selection?
5 of 20) Which fossil(s) is/are younger than fossil B?
6 of 20) These 2 plants are found on opposite ends of the world yet they share many physical traits. What do they share in common?
7 of 20) What is the problem with ligers produced from the male lion and female tiger?
8 of 20) Which type of isolation is shown in this picture?
9 of 20) Which half of this dish shows antibiotic resistance?
10 of 20) What is the process called when many species evolve from 1 original ancestral species?
11 of 20) Four part question: During the Great Bean Hunt… a. Which prey was best adapted? b. Which prey was least adapted? c. Which predator was best adapted? d. Which predator was least adapted?
12 of 20) Which isolation prevents groups of organisms from reproducing due to different seasons?
13 of 20) What are gaseous clouds that stars form from called?
14 of 20) C 12 and C 14 are both carbon because they each have 6 protons. Three part question: a) How many neutrons does C 12 contains? b) How may neutrons does C 14 have? c) C 12 and C 14 are examples of what kind of atom?
15 of 20) Place the astronomical objects in order of smallest to largest. a. Satellite b. Galaxy c. Star d. Planet e. Universe f. Solar system
16 of 20) Which isolation prevents groups of organisms from reproducing due to different mating rituals?
17 of 20) Name 3 (of the 4) gases that Miller and Urey added to their gas chamber to simulate the early atmosphere of Earth.
18 of 20) Name the two types of extinctions.
19 of 20) Two part question: a) Which body parts have lost most or all of their functions? b) Which body parts are similar in structure but differ in function?
20 of 20) Grab-Bag: Which model car has been sold the most throughout history? Volkswagen Beetle Chevrolet Corvette Toyota Corolla Ford Model T BMW 3 series